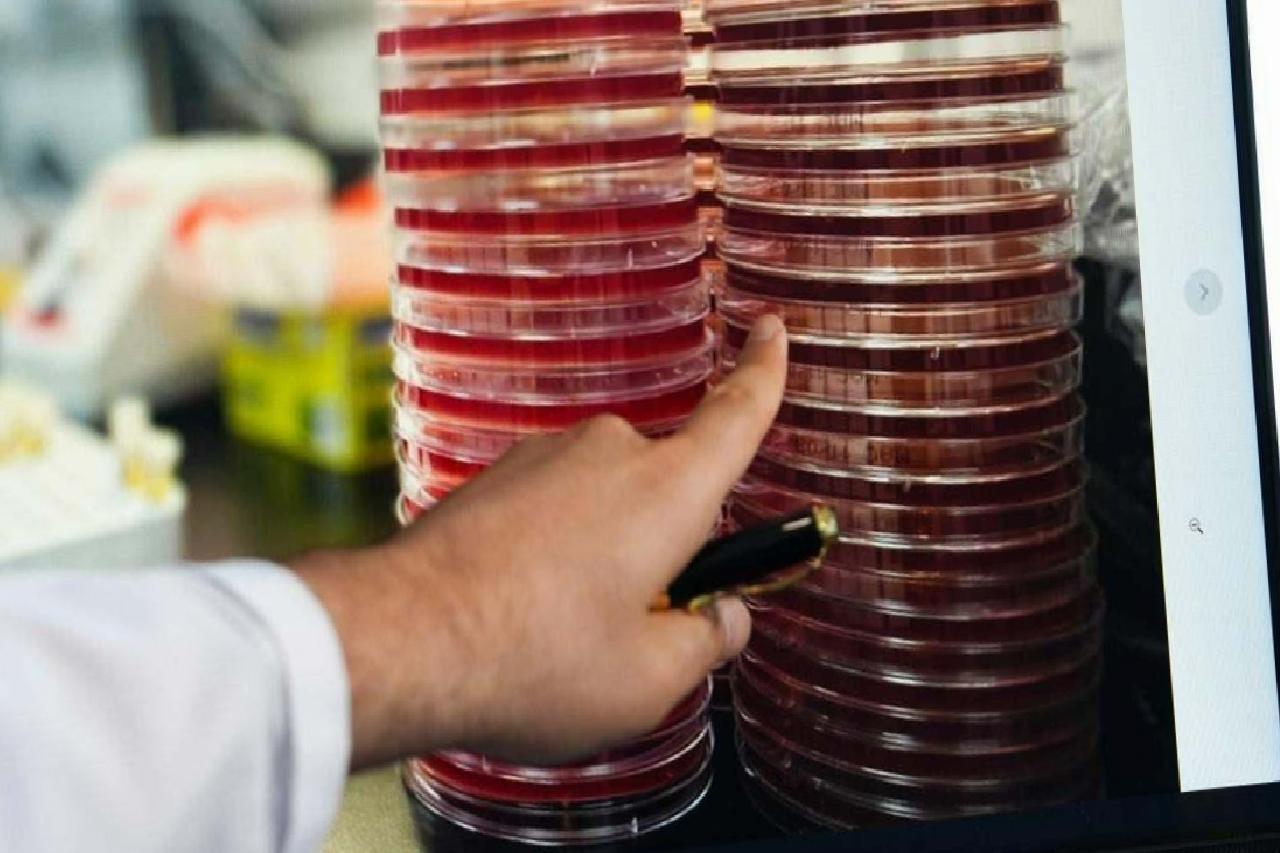
SpaceOmix Projesiyle Göz Mikrobiyomu Uzayda İnceleniyor: Uğur Tunç’un Uluslararası Katkısı

SpaceOmix Projesiyle Göz Mikrobiyomu Uzayda İnceleniyor: Uğur Tunç’un Uluslararası Katkısı

Göz yüzeyinde yaşayan mikroorganizmaların dünyamızın ötesinde nasıl davrandığını anlamaya yönelik çalışmalar, SpaceOmix projesiyle yeni bir boyut kazanıyor. Medipol Sağlık Grubu’ndan Göz Hastalıkları Uzmanı Dr. Öğr. Üyesi Uğur Tunç, bu uluslararası girişimde göz mikrobiyomunu inceleyen bilim insanları arasına katıldı ve elde edilen verilerin insan sağlığını uzay ortamında incelemeye yön vereceğini belirtti.

Göz Mikrobiyomunun Yerel ve Uzaylı Yansımaları Mikrobiyom, vücudu kaplayan bakterilerden mantarlara, virüslerden diğer mikroorganizmalara kadar geniş bir ekosistemi kapsar. Geleneksel olarak bağırsakla ilişkilendirilse de göz yüzeyi de benzer bir mikro flora barındırır. Dr. Tunç, yakın geçmişte göz yüzeyinin steril olduğu düşüncesinin değiştiğini ve yeni nesil biyoinformatik analizlerle bu bölgede yaşayan mikroorganizmaların DNA’sının şimdi daha kolay tespit edildiğini ifade ediyor.
Göz Mikrobiyomunun Bozulması ve Olası Etkileri Uzun vadede mikrobiyom dengesinin bozulması, faydalı mikroorganizmaların azalması ve zararlı patojenlerin çoğalmasıyla bazı göz hastalıklarını tetikleyebiliyor. Kuru göz, alerjik konjonktivit, üveit ve iridosiklit gibi durumlar arasında mikrobiyom dengesizliğinin bağlantılı olabileceği düşünülüyor.

Uzay Yolculuğunda Göz Mikrobiyomunun İncelenmesi Mart 2025’te FRAM-2 görevi kapsamında SpaceX’in FALCON-9 roketiyle yapılan yolculuk, göz mikrobiyomunun uzay ortamında ilk kez gözlemlenmesini sağladı. Polar yörüngede beş gün süren bu süreçte katılımcılar tarafından alınan aynı kişilere ait göz mikrobiyomu örnekleri, hem dünyada hem uzayda saklanıp karşılaştırmalı olarak analiz edildi. Dr. Tunç, projenin ana sorumlulukları arasında mikrobiyomun elde edilmesi ve analiz protokolünün oluşturulması bulunduğunu belirtti. Ayrıca Suudi Arabistan, Belçika, Malta ve Florida’dan bilim insanlarıyla işbirliği yaptıklarını ekledi.
Uzayda Mikrobiyal Davranışlar ve İnsan Sağlığına Olası Yansımaları Yerçekimi, radyasyon ve atmosfer koşulları gibi faktörlerin mikroorganizmaların DNA ve protein yapılarını etkileyebileceği düşünülüyor. Dr. Tunç, bu etkilerin insan sağlığı üzerinde yeni kapılar açabileceğini vurgulayarak şu görüşleri paylaştı: “Mikroorganizmalar, yüksek organizmalara yakınlıkları nedeniyle insana dair pek çok işlevi anlamada model oluşturabilir. Uzayda mikrobiyom davranışını incelemek, ileride uzayda uzun süre kalan insanların sağlık sorunlarını çözüme kavuşturabilir. Göz mikrobiyomunun bu alanda kilit bir rolü olabilir.”